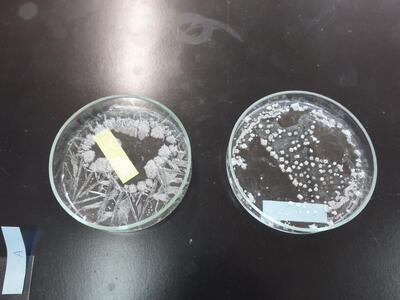

文字
背景
行間
学校の様子
紺碧祭⑤吹奏楽部
アラジン、氷の城、魔女の宅急便メドレー、学園天国を演奏しました。
迫力の演奏を披露しました。
(もしよろしければいいねボタンを押してください)
紺碧祭④合唱コンクール
合唱コンクールでは、どの学級もこれまでで最高の合唱でした。
審査員の先生方からも、どの学級も非常にレベルが高いと、お褒めの言葉をいただくほどでした。
<1年2組>「地球星歌」
<1年1組>「てのひら」
<2年1組>「群青」
<2年2組>「あさがお」
<3年1組>「あなたへ 旅立ちに寄せるメッセージ」
(もしよろしければいいねボタンを押してください)
紺碧祭③英語スピーチコンテスト
続いては英語スピーチコンテストです。
3年の鈴木利徠翔さん、2年秋山愛菜さんが発表しました。
先日の芳賀地区英語スピーチコンテストに出場した際の内容でした。
2年秋山愛菜さん「Rescued Cats」(保護猫)
3年鈴木利徠翔さん「What can we do with AI?」(AIで何ができる?)
(もしよろしければいいねボタンを押してください)
紺碧祭②オープニングセレモニー
本日紺碧祭(学校祭)が行われました。
<オープニングセレモニー>
ドラゴンクエスト風のオープニングで、会場は大いに盛り上がりました。
(もしよろしければいいねボタンを押してください)
紺碧祭①開会式
紺碧祭が行われました。
開会式では、最初に校長先生から
・それぞれの学年がこれまでしっかり成長してきた
・1・2年生は3年生を目標にしてほしい
・レベルアップを合言葉に成長した姿を見せてほしい
・思いを出し切って最高の思い出にしてほしい
というお話がありました。
次に生徒会長の大関歩果さんから、
・楽しかった、やってよかったと思える紺碧祭にしてほしい
・これまでの練習・準備で皆さんはレベルアップした
・最高の思い出にしてほしい
という激励の言葉がありました。
(もしよろしければいいねボタンを押してください)
PTA企画ポップコーン大成功!!
今回PTA会長様の発案でポップコーンを配付しました。
生徒たちは大喜びでした。
紺碧祭も含めて最高の思い出になりました。
PTAの皆様御協力ありがとうございました!
(もしよろしければいいねボタンを押してください)
紺碧祭まであと1日!
紺碧祭まであと1日となりました。
<準備>
2年生が会場準備をしました。
1年生が清掃をして、3年生は清掃と係準備をしました。
<合唱リハーサル>
最後のリハーサルを行いました。
3年生は時間の関係で明日行います。
自由発表もリハーサルをしましたが、秘密です。
明日をお楽しみに!
(もしよろしければいいねボタンを押してください)
本日の給食
★ 地産地消給食 ★
ごはん、牛乳、ポークハムカツ、元気サラダ、満点みそ汁
※写真はありません。
本日の給食
黒糖コッペパン、牛乳、あらびきチキンナ②、ビーンズサラダ、アルファベットスープ
紺碧祭まであと3日
いよいよ紺碧祭があと3日にせまってきました。
生徒たちは、今日も放課後の係活動に一生懸命取り組んでいます。
◆合唱コンクール運営係
当日の流れを確認しました。
◆ちぎり絵・シンボル画係
それぞれ着々と完成に近づいています。
◆吹奏楽部
それぞれ個人のレベルを上げる練習をしていました。
◆服のチカラプロジェクト係
準備物や仕事の分担を確認しました。
◆フォトスポット係
こちらも着々と進んでいます。
(もしよろしければいいねボタンを押してください)
本日の給食
三色ごはん(とりそぼろ・卵そぼろ・ほうれん草)、牛乳、さつまいも汁
生徒朝会(体育委員会)
本日の生徒朝会は体育委員会の発表でした。
6月に実施した新体力テストの結果を学年ごとに分析し、それぞれの弱点を補うにはどのような運動が必要かを考え発表しました。
中にはクイズもあり、生徒は楽しみながら参加することができました。
(もしよろしければいいねボタンを押してください)
今日の授業から
今日は6校時を紹介します。
◆2年1組・2年2組・3年1組 総合的な学習の時間「合唱コンクールに向けて」
今週末の合唱コンクールに向け、通称「練習試合」を行いました。
適度な緊張の中での発表、他クラスの出来栄えの確認ができ、貴重な時間となりました。
お互いに大きな刺激となりました。
この刺激が合唱を数段引き上げてくれると思います。
◆1年1組 英語「Unit6を振り返る」
Unit6の文法を、例文を元にして振り返りました。
◆1年2組 理科「混合物をエタノールと水に分ける方法を知ることができる」
エタノールと水の混合物を分けることができて、そのエタノールを燃焼させて確かめました。
◆1年4組 社会「家の工作」
家の形を考えて工作しました。
(もしよろしければいいねボタンを押してください)
お弁当の日
今日はお弁当の日です。
今日も学級ごとにお弁当を食べました。
<2年2組>
<2年1組>
<1年1組>
<3年1組>
<1年2組>
(もしよろしければいいねボタンを押してください)
今週末は紺碧祭です
いよいよ今週末に紺碧祭が行われます。
今週は準備週ということで部活動を中止にして、係活動に取り組んでいきます。
◎自由発表(運営)係
準備物や流れの確認をしました。
◎服のチカラプロジェクト係
集め方などこれからの流れを確認しました。
集める箱なども準備しました。
◎フォトスポット係
流れの確認をしていました。新しい企画ですので期待してください。
◎シンボル画・スローガン係
シンボル画・ちぎり絵とも少しずつ完成に近づいてきました。
※その他の係の写真はありませんが、一生懸命取り組んでいました。
(もしよろしければいいねボタンを押してください)
今日の授業から
今日は4校時を紹介します。
◆2年2組 技術「栽培記録を作成しよう」
ブロッコリーとキャベツの世話(除草など)をしたり、写真を撮ったりして栽培記録を作成しました。
◆2年1組 家庭「ティッシュケースを作ろう」
ミシンが少しずつ津上手になってきました。
◆3年2組 国語「プリント学習」
それぞれの課題に合わせてプリントを進めました。
◆1年4組 国語「説明的文章」
教科書の読み取りを行いました。
◆1年1組 社会「韓国は、日本とどのような関りがあり、どのように産業が発展したか、理解する」
韓国のイメージを考えましたが、食べ物ばかりで盛り上がりました。
◆1年2組 数学「比例の関係について、x・yの増減を考えよう」
変化の割合を班で相談して、意見を発表しました。
◆3年1組 国語「友達の意見文を評価しよう」
班になってお互いの意見文を発表しあい、
(もしよろしければいいねボタンを押してください)
本日の給食
ごはん、牛乳、野菜とハムのマリネ、根菜のカレー、ミニフィッシュ
本日の給食
ごはん、牛乳、いわしのみそ煮、磯辺あえ、とり肉じゃが
本日の給食
★ 中村小学校リクエスト給食 ★
ミルク食パン、牛乳、オムレツ、ごぼうサラダ、フルーツポンチ
ちぎり絵・シンボル画作成中
ちぎり絵・シンボル画とも原画を大きな布や紙に投影して拡大しています。
拡大したものに色紙を貼ったり、色を塗ったりして仕上げていきます。
完成をお楽しみにしてください。
(もしよろしければいいねボタンを押してください)
今日の授業から
今日は4校時を紹介します。
◆2年1組・2組 総合的な学習の時間「事業所へのお礼状の確認」(道徳と交換)
午後に各事業所にお礼状を届けに行く準備をしました。
◆1年2組 国語「意見と根拠について知ろう」
図書室に漫画を置いていいかどうかというテーマを設定し、根拠をもって意見を言うことを学びました。
◆1年1組 数学「xの値とyの値の増加と減少について調べよう」
値が変化している表をもとに、変化する割合を調べることができました。
◆1年4組 国語「漢字の復習」
苦手な漢字の練習に挑戦しました。
◆3年1組 道徳「外国から来た転校生」
動画を視聴するなどして、文化や考えの違いに対して、どう捉えるか考えることができました。
◆3年2組 自立活動「サツマイモを収穫しよう」
これまで育ててきたサツマイモを収穫しました。
たくさん収穫できました。
紺碧祭にて販売予定です。
(もしよろしければいいねボタンを押してください)
朝会(校長講話)
本日の朝会は校長講話でした。
校長先生から「プラス受信」について講話をいただきました。
・何事も前向きに考えればチャンスになる。後ろ向きに考えればピンチになる。
・あらゆる出来事をプラスに受け止める発想法
・チャンスにできない出来事はない
・パナソニックの松下幸之助さんの考え方
・「プラス受信」でピンチをチャンスに変えて活躍してほしい
プラス受信を生かして様々な場面で活躍してほしいと思います。
(もしよろしければいいねボタンを押してください)
本日の給食
ごはん、牛乳、肉しゅうまい②、もやしの韓国風サラダ、卵とわかめのスープ、いちごゼリー
県新人陸上競技大会
下野市の大松山運動公園陸上競技場で行われました。
結果は次のとおりです。
2年女子
日下田 心那さん 800m 第6位(入賞)
手塚 千結さん 100m 予選通過ならず
手塚 千結さん 200m 予選通過ならず
大塚 梨奈さん 砲丸投 予選通過ならず
御声援ありがとうございました。
(もしよろしければいいねボタンを押してください)
本日の給食
コッペパン、牛乳、野菜コロッケ・ソース、ブロッコリーサラダ、マリガトーニスープ
進路説明会
5・6校時3年生の進路説明会を行いました。
前半は私立高校の先生方による説明、後半は本校職員による県立高校入試の説明を行いました。
前半は事前に希望をとり、希望に沿った私立高校の話を聞きました。
後半は本校職員が、今年度から変更になる県立入試のポイントを中心に説明しました。
◆前半(私立高校説明)
◆後半(県立高校説明)
(もしよろしければいいねボタンを押してください)
今日の授業から
今日は4校時を紹介します。
自由参観日のため保護者の方も来校されました。
◆2年1組 数学「1次関数を使って図形の問題を解こう」
図形の辺を移動する点によって変化する面積などの問題を、1次関数の式を立てて解きました。
◆1年2組 英語「彼・彼女が言える」
いろいろな人称について、どのように表現するか学習しました。
◆1年1組 社会「アジア州は地形や気候にどのような特徴が見られる地域か理解する」
地形の学習として、各半島の名前を白地図で確認しました。
◆3年2組 国語「プリント学習」
文章の読み取りや漢字などを学習しました。
◆1年4組 数学「関数を知ろう」
電子黒板で変化の割合を確認しながら学習しました。
◆3年1組 英語「関節疑問文をドリルパークで解こう」
電子黒板の音声を聞き取り、カフートを使って盛り上がって振り返りました。
◆2年2組 美術「ポスターで伝えよう」
自分が伝えたい内容の原案をスケッチしました。
(もしよろしければいいねボタンを押してください)
本日の給食
ラーメン、牛乳、春巻、春雨サラダ、麻婆ラーメンスープ
本日の給食
食パン、ミックスジャム、牛乳、オニオンソース肉団子②、アーモンドサラダ、コーンポタージュ
本日の給食
ごはん、牛乳、とり肉の朝鮮焼き、切干大根のナムル、生揚げのそぼろ煮
合唱コンクール練習本格スタート
合唱コンクールに向け、練習が本格的にスタートしました。
グランドピアノがある音楽室・体育館・多目的室を公平に割り当て練習していきます。
練習は朝、昼休み、放課後を中心に練習します。
昼休みは3年生が体育館で練習していました。
これからどんどん仕上がっていくのが楽しみです。
(もしよろしければいいねボタンを押してください)
本日の給食
コッペパン、牛乳、スラッピージョー、花野菜サラダ、チキンヌードルスープ
2学期中間テスト2日目
今日は昨日と比べて、一気に涼しくなりましたね。
過ごしやすい日に生徒達は集中して中間テストに取り組んでいます。
<1年1組>
<1年2組>
<2年1組>
<2年2組>
<3年1組>
(もしよろしければいいねボタンを押してください)
2学期中間テスト1日目
中間テストが始まりました。
集中して取り組んでいます。
<1年1組>
<1年2組>
<2年1組>
<2年2組>
<3年1組>
(もしよろしければいいねボタンを押してください)
本日の給食
★ 十五夜給食 ★
ごはん、牛乳、野菜かき揚げ・天丼のたれ、菊花あえ、けんちん汁、山形県産ふじりんごゼリー
今日の授業から
今日は4校時を紹介します。
◆2年2組 美術「ポスターで伝えよう」
インターネットを活用しながらアイディアスケッチをしました。
いろいろなアイディアを吸収し、発想を膨らませることができました。
◆1年1組 社会「国づくりが行われていった古代の社会にはどのような特色があったの説明する」
政治や文化、外交などについて特徴をまとめました。
◆3年2組 国語「プリント学習」
2人とも課題が早く終わり、次の活動を行いました。
◆1年4組 数学「方程式に挑戦しよう」
方程式の解き方を学び、たくさんの問題を解きました。
◆1年2組 英語「リスニングをしよう」
来週の中間テストに向けてリスニングの問題を解きました。
◆2年1組 数学「関数のグラフを利用していろいろなことを読みとろう」
速さの異なる2人が同時に走り出し、◯分後に出会うという有名な問題に挑戦しました。
◆3年1組 英語「間接疑問文を極めよう!」
英語の歌を聴いて、どんな表現がされているか聞き分けました。
なかなか難しく盛り上がりました。
(もしよろしければいいねボタンを押してください)
本日の給食
セルフキムタクごはん、牛乳、キャベツのおかかあえ、かきたま汁
大内資料館見学
本日4校時、1年生が総合的な学習の時間に大内資料館を見学しました。
地域学習の一環になります。
地域の黒﨑さん、梁木さん、大塚さんに、大内地区の古代のジオラマや、土器などの出土品、資料などを丁寧に御説明いただきました。
生徒達は真剣に耳を傾け、メモをとっていました。
きっと新しい発見があったと思います。
これらの情報を持ち帰り、さらに調査を続、研究を深めていきたいと思います。
なお、真岡新聞・下野新聞の取材がありましたので、近日中紹介されると思います。
(もしよろしければいいねボタンを押してください)
駅伝練習再開
10月28日の駅伝大会に向けて、朝練を再開しました。
(もしよろしければいいねボタンを押してください)
委員会活動
本日実施した委員会活動を紹介します。
◆環境委員会
アルミ缶回収とアルミ缶回収強化週間のポスター作りを行いました。
◆文化委員会
ポスターの張り替えを行いました。
◆校紀委員会
いじめ撲滅宣言ポスターや自転車点検を行いました。
◆衛生委員会
生徒朝会の練習をしました。
◆体育委員会
こちらも生徒朝会の準備をしました。
◆生徒会本部役員
紺碧祭の準備・確認をしました。
(もしよろしければいいねボタンを押してください)
今日の授業から
今日は5校時を紹介します。
◆1年2組 音楽「合唱練習をしよう」
パートに分かれて、合唱の練習を進めました。
徐々に精度が上がってきています。
◆2年1組 国語「五段活用」
古典の活用を学習しました。
2年2組 自習
中間テストが近いため、それぞれ問題集などを活用していました。
◆1年1組 数学「一方の値を決めると他方の値も決まる関係について調べよう」
駐輪料金と駐輪時間との関係を、グループで議論しながら考えました。
◆1年4組 数学「不等号」
教科書の問題を丁寧に解くことができました。
※3年生は画像がありません。
(もしよろしければいいねボタンを押してください)
本日の給食
はちみつパン、牛乳、ごぼう入りバーグ、コールスローサラダ、ミネストローネスープ
現職教育「教育相談」
放課後、現職教育として「教育相談」研修をしました。
講師に本校スクールソーシャルワーカーの手塚先生を迎え講話をしていただきました。
いろいろなエピソードを交えてお話いただきました。
今後の指導に生かしていきます。
本日の給食
ごはん、牛乳、ホッケ文化干、ひじきの炒め煮、野菜のみそ汁
今日の授業から
今日は5校時を紹介します。
※2学年は体調不良者が増えてきているため、給食後下校しました。
◆1年1組 理科「結晶として取り出せる量を考えることができる」
まずは結晶の形を確認し、その後取り出し方を学習しました。
◆1年2組 社会「平安時代にはどのような特徴をもった文化が展開したか理解する」
枕草子などの平安時代の文化を学習しました。
枕草子は随筆なので、現代に置き換えると…? 答えは生徒からお聞きください。
◆3年1組 総合的な学習の時間「紺碧祭に向けて」
紺碧祭の係分担を決めました。
3年生のリーダーシップに期待しましょう。

(もしよろしければいいねボタンを押してください)
本日の給食
丸パン、牛乳、焼きチキンカツ、ブロッコリーとツナのサラダ、マカロニのクリーム煮
今日の授業から
今日は4校時を紹介します。
◆2年1組 家庭「ミシンを使いこなそう」
今日もボランティアの方がたくさん協力して教えてくださいました。
少しずつ上達しています。
◆3年2組 国語「プリント学習」
プリントを使って、よりよい文章について学習しました。
◆1年4組 国語「さんちき」
教科書を丁寧に朗読しました。
◆1年1組 社会「平安時代に行われた政治にはどのような特色があったか説明する」
平安京など、当時の都で行われていた政治について学習しました。
◆1年2組 数学「比例式について理解しよう」
比について確認しました。
分数は苦手な生徒が多いです。
◆2年2組 技術「リーフレタスの栽培記録をつくろう」
先週植えたリーフレタスの栽培記録をタブレットでまとめました。
◆3年1組 英語「間接疑問文をマスターしよう!」
疑問文をつなげて間接疑問文を作りました。
(もしよろしければいいねボタンを押してください)
本日の給食
ごはん、牛乳、焼きぎょうざ②、中華くらげサラダ、マーボー豆腐
芳賀郡市新人大会結果
9月26日(金)~27日(土)に行われた新人大会の結果をまとめました。
バレーボール 準優勝 県大会出場
剣道 男子団体 第4位 県大会出場
男子個人 2年 武田賢人さん 県大会出場
サッカー 第3位
野球 ベスト8
ソフトテニス 女子団体 予選敗退
女子個人 大金・小坂ペア3回戦敗退
御声援ありがとうございました。
なお、県大会につきましては、以下の日程で行います。
陸上競技 10月14日(火)大松山運動公園陸上競技場
バレーボール 10月17日(金)~19日(日)DAIKYOアリーナさの・茂木町民体育館のいずれか(抽選による)
剣道 10月17日(金)午後男子団体・18日(土)午前男子個人 県北体育館
県大会も引き続き御声援をよろしくお願いいたします。
今日の授業から
今日は6校時を紹介します。
◆1年2組 理科「溶質の取り出し方を確認することができる」
再結晶やろ過など、溶けている物質を取り出す方法を考えることができました。
◆2年1組 音楽「合唱練習」
パート毎に練習をしました。少しずつ仕上がってきています。
◆3年2組 社会「沖縄について知ろう」
沖縄の地理や歴史についてプリントを使って学習しました。
◆1年4組 英語「三単現を練習しよう」
He lives ~ など、三単現の使い方を練習しました。
◆1年1組 国語「全文を読んで内容を大まかにつかむ」
ワークを使って漢字などの復習をしています。
◆2年2組 数学「2元1次方程式のグラフを書けるようにしよう」
y=4などのグラフも書けるように練習しています。
◆3年1組 社会「日本国憲法が社会権を保障しているのはなぜか考える」
社会権について具体例を参考にしながら学習しました。
(もしよろしければいいねボタンを押してください)
出席停止関係書類(インフルエンザ以外)の様式は、各種おたよりのページからダウンロードできます。
大内中学校のシンボルキャラクター「モーウチモカウ」くんです。
~3月~「卒業おめでとうございます」〜
イラスト作:Mirai
歴代モカウは→歴代モカウの部屋
~創立記念バージョン~
作:Mirai Tomiyama
【プロフィール】
・名前の由来:モー(牛の鳴き声)ウチ(大内の内〈ウチ〉)モ(真岡〈モオカ〉のモ)カウ(cow〈英語で牛という意味〉)
・誕生日:4月28日(大内中の創立記念日と同じ)
・属性:大内の妖精
・性別:不詳
・趣味:日なたぼっこをしながら寝ること
ご相談のある方は、いつでもご連絡ください。担当:東瀬
【令和7年度来校日】原則金曜日
《1学期》
4月25日・5月30日・7月11日
《2学期》
9月19日・10月17日・11月28日・12月19日
《3学期》
1月30日・2月27日
上記の日程以外でも大内地区内の小学校で利用できるよう調整可能です。